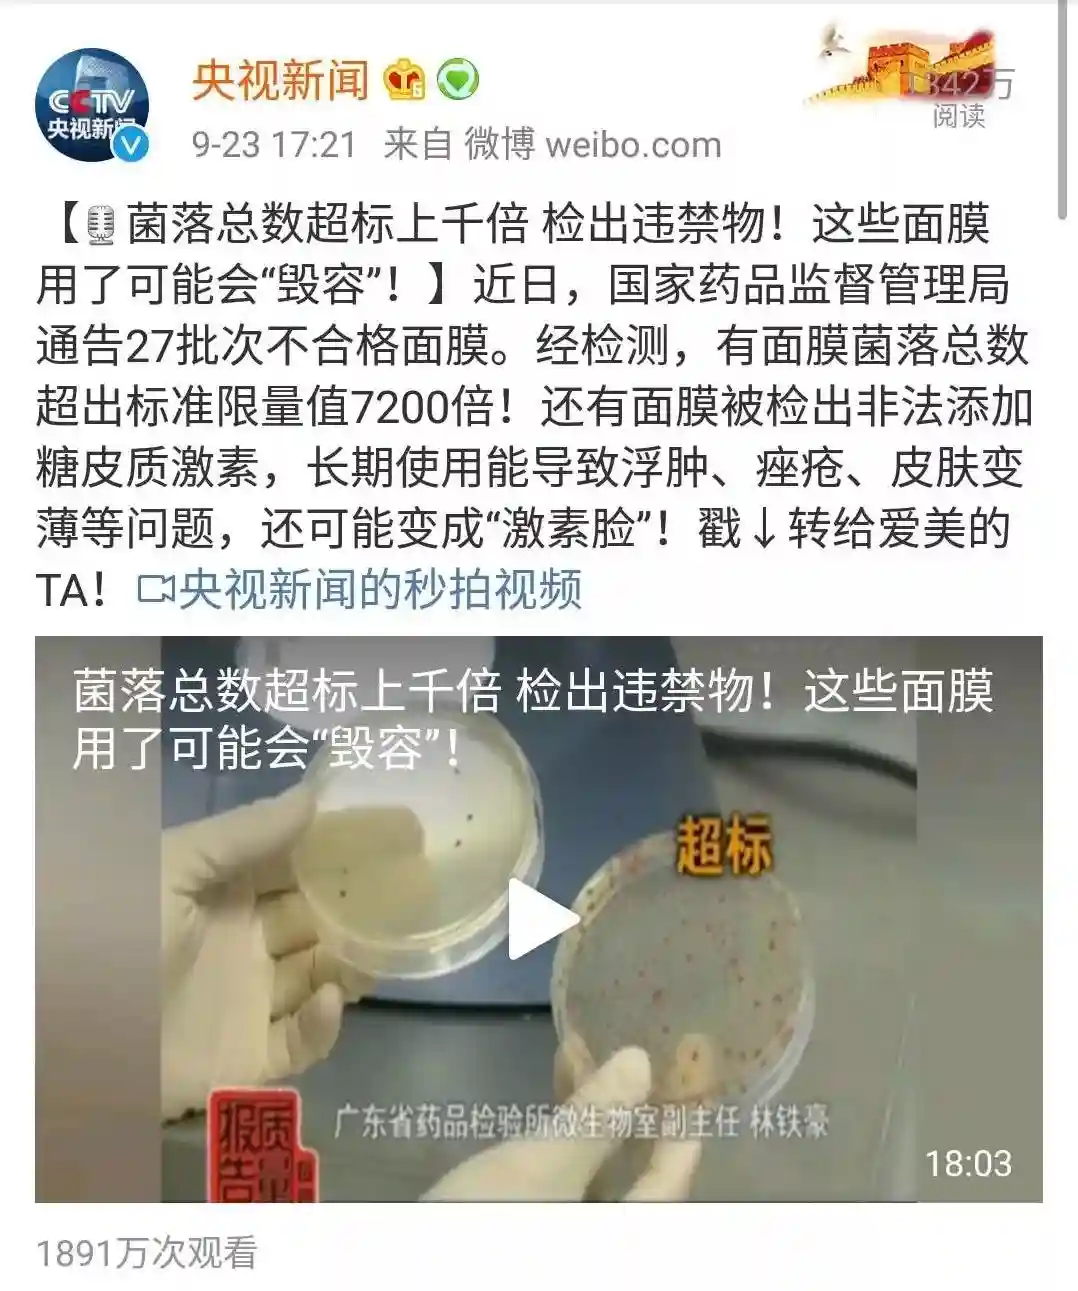

但是!前有抖音护肤查出致癌!后有国家药监局查出27批次面膜不合格!
经药监局检测发现:其中有样品面膜菌落总数超出标准限量值7200倍!还有面膜被检出非法添加糖皮质激素!
它可以反应加工环节卫生状况的优劣!可以想象,菌落总数超标7200倍,加工厂的环境会是多么恶劣!

糖皮质激素短时间是可以抗炎的,but只能抑制而不能治愈,一旦停用便立刻复发甚至恶化肌肤状态。
反反复复折磨肌肤最终变成激素依赖性皮炎,也就是我们俗话常说的烂脸了!所以被划分到国家化妆品禁用组分中。

天啊!这个世界还能不能让我们可爱的美少女好好护肤啦!
然鹅,即使产品没问题,护肤也绝不是三天打鱼两天晒网,敷面膜看上去简单,但也是一门复杂的功课。
虽然小编在护肤上比较懒,但是敷面膜可以说是小编坚持多年的好习惯,所以在这方面也有一点心得。
今天呢,小编就给大家带来的一款是小编在家经常翻牌子的面膜:韩国JM加海洋珍珠保湿三部曲面膜!绝对的“三有产品”!

从今年夏天韩国JM公司以方便携带的防晒棒火了之后,就一发不可收拾。
拥有了JM产品那就是潮流的象征,成为了网红必备款。
被美妆博主推烂了的JM家这次又出了新款面膜,竟然是三部曲,被称为“懒人妹子福音”!

性价比超高
01
价格白菜
比很多普通的补水面膜都便宜许多,但是它却能补水,还美白,一白遮百丑,反正小编敷完感觉自己白到发光!
02
三部曲
可能各位仙女身边有了化妆水、乳、防晒等等护肤品……却唯独缺了精华和眼霜。

今天JM就能满足你,大家可能都听说过女生18岁就要涂眼霜了,否则眼睛细纹长出来,以后即使用再贵的护肤品也很难抹平它,
所以拥有了三部曲就是拥有了一切!
那么,如何使用这款面膜呢?
Step1:卸妆、洁面、涂抹精华
精华的半乳状半透明的质地,满满的水分感,渗透力好,吸收特别快,涂完后皮肤就有一层光泽感,一点都不油腻。


Step2:敷面膜
享受15-20分钟揭开,皮肤干燥起皮暗沉松弛统统退散,满满的保湿力与弹力

Step3:用清水冲洗脸部,涂抹眼霜(还可当面霜涂全脸)
这个眼霜是全效的,可以涂眼周、脸部、颈部、无论是眼角细纹、法令纹、还是颈纹统统可以提拉紧致。


涂完感觉皮肤封了一层蜡,所有养分都被锁住了一样,如果是其它面膜一定感觉油腻死,但是这款完全不会,小编超爱这一点!
如果喜欢此款商品,可以到全球时刻商城购买哦!
直邮JMsolution海洋珍珠深层保湿三部曲面膜10片/盒
活动价:69元
市场售价:169元

更多苛选好物,
尽在全球时刻,
为你创造精致生活!

免责声明:本文章如果文章侵权,请联系我们处理,本站仅提供信息存储空间服务如因作品内容、版权和其他问题请于本站联系